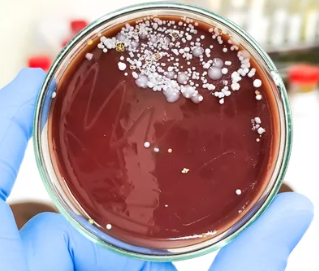

질건조증 – 증상, 원인 및 치료 방법
- 카테고리 없음
- 2025. 2. 17. 21:30
질건조증 – 증상, 원인 및 치료 방법
질건조증은 질 내 점막의 수분 부족으로 인해 건조함, 가려움, 따가움 등의 불편함이 발생하는 질환이다.
특히 폐경기 여성, 호르몬 변화, 스트레스, 특정 약물 복용 등이 주요 원인으로 작용할 수 있다.
이번 글에서는 질건조증의 주요 증상, 원인, 치료 방법 및 예방 방법을 소제목 5개로 정리하여 설명하겠다.
1. 질건조증의 주요 증상



✔ 질 내 건조함 – 윤활 부족으로 인해 불편함 증가
✔ 따가움 & 가려움 – 점막 손상으로 인해 자극 발생
✔ 성관계 시 통증(성교통) – 자연 윤활 부족으로 인해 마찰 증가
✔ 질 점막 염증 – 세균 감염 위험 증가로 질염 발생 가능
✔ 소변 시 따가움 – 질 점막이 얇아지면서 자극 증가
📌 즉, 질건조증의 주요 증상은 건조함, 가려움, 따가움, 성교통, 감염 위험 증가 등으로 나타날 수 있다.
2. 질건조증이 발생하는 주요 원인



① 여성호르몬(에스트로겐) 감소 – 폐경기 & 출산 후 변화
✔ 폐경 후 에스트로겐 감소 → 질 점막 위축 & 윤활 감소
✔ 출산 후 & 수유 중 호르몬 변화 → 일시적인 질건조증 발생 가능
② 스트레스 & 과도한 다이어트 – 신체 균형 변화
✔ 스트레스 호르몬 증가 → 생식기 혈류 감소 & 질 분비물 감소
✔ 영양 불균형(단백질 & 필수 지방산 부족) → 점막 보습 기능 저하
③ 특정 약물 부작용 – 항히스타민제 & 항우울제 영향
✔ 항히스타민제 – 점막 건조 부작용(알레르기 약 포함)
✔ 항우울제 & 피임약 – 에스트로겐 균형 변화로 건조증 유발 가능
④ 세정제 & 잦은 질 세척 – 질 내 균형 변화
✔ 질 내부를 과도하게 세척하면 유익균 감소 & 점막 보호 기능 저하
✔ 향이 강한 비누 & 세정제 사용 시 점막 자극 가능
📌 즉, 질건조증의 주요 원인은 여성호르몬 감소, 스트레스, 특정 약물, 과도한 세정 등이 있다.
3. 질건조증 치료 방법 – 약물 & 생활습관 개선



① 호르몬 요법(폐경기 여성 치료)
✔ 국소 에스트로겐 크림 – 질 내부 점막 회복 & 윤활 증가
✔ 에스트로겐 질정(좌약) – 점막 건강 유지 & 건조함 완화
✔ 경구 호르몬 치료(의사 상담 후 진행 필요)
② 질 보습제 & 윤활제 사용
✔ 질 보습제 – 점막 보습 효과 & 장기간 수분 유지(약국 구매 가능)
✔ 수용성 윤활제 – 성관계 시 통증 완화 & 자극 방지
③ 생활 습관 개선 – 자연적인 점막 보호 기능 강화
✔ 충분한 수분 섭취(하루 2L 이상) – 점막 보습 유지 도움
✔ 필수 지방산 섭취(연어, 아보카도, 견과류) – 점막 건강 강화
✔ 향이 강한 비누 & 질 세정제 사용 제한
📌 즉, 치료 방법으로는 호르몬 요법, 질 보습제 사용, 생활습관 개선 등이 있다.
4. 질건조증 예방 방법 – 생활 습관 관리 필수

✔ 과도한 질 세정 피하기(질 내부 유익균 보호 필수)
✔ 균형 잡힌 식습관 유지(비타민 E & 필수 지방산 섭취 추천)
✔ 충분한 수면 & 스트레스 관리 – 신체 호르몬 균형 유지
✔ 면 소재 속옷 착용 – 통기성 유지 & 질 환경 보호
✔ 성관계 전 충분한 전희 – 자연 윤활 증가 효과
📌 즉, 질건조증 예방을 위해서는 올바른 질 관리 & 건강한 생활습관이 중요하다.
5. 병원 방문이 필요한 경우 – 의사 상담 필수



✔ 질건조증이 지속되면서 성교통 & 통증이 심할 때
✔ 소변 시 지속적인 따가움 & 불편함이 증가할 때
✔ 질염(냄새, 분비물 변화, 가려움) 증상이 동반될 때
✔ 폐경기 이후 건조증이 심해 일상생활에 지장이 있을 때
📌 즉, 증상이 지속되거나 불편함이 심하면 병원에서 적절한 치료를 받아야 한다.
6. 결론 – 질건조증 요약 정리
✅ 주요 증상: 질 건조함, 따가움, 가려움, 성교통, 감염 위험 증가
✅ 발생 원인: 폐경기 호르몬 감소, 스트레스, 특정 약물, 과도한 질 세정
✅ 치료 방법: 호르몬 요법, 질 보습제 사용, 생활습관 개선
✅ 예방 방법: 질 건강 관리, 건강한 식습관, 수분 섭취, 스트레스 관리
✅ 병원 방문 필요: 심한 성교통, 지속적인 따가움, 질염 증상 동반 시
📌 질건조증은 생활습관 개선 & 적절한 치료를 병행하면 효과적으로 관리할 수 있다.